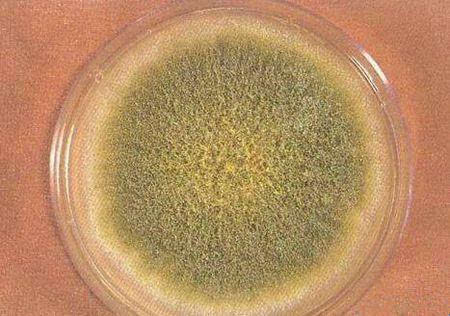

客戶服務熱線
010-83659275
-

美谷分子MD ImageXpress Confocal HT.ai 智能化共聚焦高內涵成像分析系統
- ImageXpress Confocal HT ai 智能化共聚焦高內涵成像分析系統采用了具有 8 個成像通道的 ...
-

- LAUDA導熱液體:滿足您恒溫器的安全和可靠的運行。極端溫度下高精度的溫度控制,可靠和長時間穩...
-

- LAUDA浸入式冷卻器ETK 30和ETK50緊湊的浸入式冷卻器配備有高質量不銹鋼制成的冷卻盤管。和加熱...
-

- LAUDA穿流式冷卻器風冷卻、全封閉并且免維護的冷卻單元,擁有很緊湊的換熱器,并且使用聚酯保溫...
-

LAUDA Proline校驗恒溫器:溫控范圍-40到300C
- LAUDA Proline校驗恒溫器:提供溫度范圍從-40到300C的校準和調整。LAUDA Proline高溫度到300C...
-

LAUDA Ecoline校驗專用恒溫器:應用于校準和調節溫度
- LAUDA Ecoline校驗專用浴槽Ecoline Staredition可以提供低溫在-30℃時的溫度穩定性達到±0 01...
-

LAUDA UItracool工藝過程冷卻水循環器:-5到25℃
- LAUDA UItracool工藝過程冷卻水循環器:提供高達265kW的制冷功率,溫度范圍從-5到25℃滿足工業...
-

LAUDA Varnocool冷卻水循環器:控溫范圍-20到40℃
- LAUDA Variocool功率高到10kW,溫度從-20到40℃,用來帶走實驗室設備、小型工廠和生產區產生的...
地址:北京市豐臺區西四環南路46號國潤商務大廈2605室
郵編:100073
1960 年,英國發現有 10 萬只火雞死于一種以前沒見過的病,被稱為“火雞 X 病”,追根溯源,最大的嫌疑是飼料。這些火雞和鴨子吃的是花生餅。這些花生餅被一種來自真菌的有毒物質污染,經過進一步研究和確認后,人們發現了是黃曲霉( Aspergillus.flavus )產生的有毒代謝物質,黃曲霉毒素( Aflatoxins )。

從化學結構上看,黃曲霉毒素是高度取代的香豆素。黃曲霉毒素在長波紫外光下產生熒光,根據熒光顏色、RF值及結構不同等分別命名為 B1,B2,G1,G2,M1,M2,P1,R1,GM 和毒醇。其中以 B1 的產量最高,毒性最大,致癌性最強, G1 和 M1 的毒性次之。

圖 1 .部分黃曲霉毒素的結構
極強的致癌物
黃曲霉毒素廣泛存在于自然界中,在濕熱地區食品和飼料中出現黃曲霉毒素的機率最高。它們存在于土壤、動植物、各種堅果中,特別是容易污染花生、玉米、稻米、大豆、小麥等糧油產品,是霉菌毒素中毒性最大、對人類健康危害極為突出的一類霉菌毒素。
黃曲霉毒素對人類健康的危害主要是由于人們食用被黃曲霉毒素污染的食物,包括受黃曲霉毒素(主要為 B1 )污染的植物性食物攝入,以及經飼料而進入奶或乳制品(包括乳酪、奶粉等)的黃曲霉毒素(主要為 M1 )。黃曲霉毒素 B1 的半數致死量為 0.36 mg/kg 體重,屬特劇毒的毒物范圍,它引起人的中毒主要是損害肝臟,發生肝炎、肝硬化、肝壞死等。臨床表現有胃部不適、食欲減退、惡心、嘔吐、腹脹及肝區觸痛等;嚴重者出現水腫,昏迷,以致抽搐而死。
2017 年 10 月 27 日,世界衛生組織國際癌癥研究機構公布的致癌物清單初步整理參考,黃曲霉毒素在一類致癌物清單中。
鑒于黃曲霉毒素對人類的巨大危害性,全世界各國都針對黃曲霉毒素檢測出臺了相應的標準,目前國際上對各種食品、農產品、飼料中黃曲霉毒素含量的檢測已成為強制的措施;近年來,隨著科學技術的不斷發展,黃曲霉毒素的檢測方法從最初以薄層層析法為主,發展到高效液相色譜法、微柱法、酶聯免疫吸附法等多種方法普遍應用:
薄層層析法( TLC )是測定黃曲霉毒素的經典方法,其原理是將樣品經過提取、柱層析、洗脫、濃縮、薄層分離后,在波長 365nm 紫外光下產生藍紫色或黃綠色熒光,并根據其在薄層上顯示的最低檢出量來確定其含量。其不足之處在于傳統 TLC 的樣品前處理繁瑣,實驗過程較復雜,耗時長,且受樣品提取、 純化、展開、分離等多種因素的影響,精確性較差,安全性欠佳,因此逐漸被其他檢測方法所取代。
高效液相色譜法( HPLC )近幾年發展起來的檢測 AFB1 的方法,其原理是樣品溶液中欲分離的幾種化合物在流動相和固定相之間有不同的分配量,從而達到分離的目的。黃曲霉毒素經柱后電化學衍生化后,能發射特征性熒光,被熒光檢測器捕獲后而得到檢測,最后經化學工作站處理數據。該方法具有高效快速、定量準確、靈敏度高、檢測限低等優點,是目前測定黃曲霉毒素比較權威的方法,但是該方法需要昂貴的儀器設備,需要專門的技術人員操作,難以滿足現場化的要求。
微柱篩選法的原理是樣品提取液通過由硅鎂吸附劑和氧化鋁組成的微柱層析管后,黃曲霉毒素被硅鎂吸附劑吸附,雜質被氧化鋁吸附。在紫外燈下觀察結果,將層析后的樣品管依次與 0 、5 和 10ng 的 AFB1 標準管比較。如果樣品管內硅鎂吸附劑層與 0ng 標準管一致,則為陰性( 5μg/kg 以下),如果呈現藍紫色熒光,則為陽性。此方法優勢在于微柱篩選法設備簡單、操作簡便。不足之處在于微柱不能分離 B1、B2 、G1 和 G2 。所以,該方法只能檢測黃曲霉毒素的總量,是一種適用于樣品快速篩查的定性檢測方法。
免疫法是以抗原抗體的免疫化學反應為基礎進行抗原抗體含量測定的方法,為利用具有高度專一性的單克隆抗體或多克隆抗體設的黃曲霉毒素的免疫分析方法。目前也是最常用的黃曲霉毒素檢測方法,該類方法具有高度特異性、靈敏性、快速簡便、分析費用低、重復型好、短時間內處理大量樣品和易于普及等優點。這類方法主要包括放射免疫分析方法,免疫層析法、熒光光度法(免疫層析柱凈化—熒光光度法)及酶聯免疫法。它們均可以對黃曲霉毒素進行定性和定量測定。
在免疫法中,酶聯免疫吸附法( ELISA )是一種常見的、成本相對較低的食品和飼料樣品中霉菌毒素檢測方法,利用抗原-抗體反應的高特異性和酶促反應的高敏感性實現對抗原或抗體的檢測。ELISA 有直接競爭和間接競爭兩種模式,可用酶標儀進行結果判讀,通量高,極大地節約時間和成本。
下面以檢測大麻中黃曲霉毒素的水平為例,闡述ELISA 試劑盒與酶標儀的聯用。
 優點
優點
-
節約時間和成本,高通量、低成本的 ELISA 方法
-
在單個提取物中分析多種黃曲霉毒素
-
使用 SoftMax Pro 軟件可以快速評估結果
材料-
AgraQuant Total Aflatoxin 4/40 ELISA 試劑盒 ( Romer Labs cat. #10002098 )
-
AflaStar R Rapid Clean-Up IAC 柱子 ( Romer Labs cat. #10001963 )
-
Aflatoxin B1 Standard 標準品 ( Sigma cat. #34029 )
-
Cannabis flower 大麻的花卉 ( 加州藥房獲取 )
-
Methanol, HPLC grade 甲醇,HPLC級 (Sigma cat. #34860)
-
Ammonium acetate 醋酸銨 ( Sigma cat. # 73594 )
-
SpectraMax ABS Plus 酶標儀 ( Molecular Devices )
-
SpectraMax iD5 多功能酶標儀 ( Molecular Devices )
制備樣品將大麻樣本放在一個塑料袋里,用手壓碎。稱量 1 克樣本并將其放入 4 個 50mL 的錐形管中。然后在樣本中分別添加 0、10、20 和 30 ppb 黃曲霉毒素 B1 標準品。再加入 20mL 70% 甲醇至樣本中,劇烈渦旋 3 分鐘。所得提取物通過 Whatman 1 級濾紙過濾到干凈的 50mL 錐形管中。
在每一個提取、過濾得到的樣品中,吸取 4mL 至干凈的錐形管中,并加入 20 mL 去離子水。總的 24mL 溶液通過免疫親和層析柱( IAC )純化。樣品中的黃曲霉毒素與層析柱中的抗體選擇性結合。用 20mL 0.5M 醋酸銨沖洗柱子,將未結合的物質沖洗掉。最后用 1mL 100% 甲醇洗脫樣品,收集于干凈的試管中。
黃曲霉毒素 ELISA 檢測方法
每個標準品和待測樣品的稀釋孔做三個重復,放置于微孔板條固定器中。將等量抗體包被的微孔放置在單獨的板條固定器( ELISA 板)中。未使用的微孔放回帶有干燥劑的鋁箔袋中。
每個稀釋孔加入 100uL 的偶聯物,然后加入 50uL 黃曲霉毒素標準品或待測樣品。根據試劑盒方案,偶聯物與樣品保持 2 :1 的比例。孔內溶液用 8 通道移液器混合均勻。每種稀釋溶液取 100uL 轉移到 ELISA 板的抗體包被過的微孔中,室溫孵育 15 分鐘。
孵育后,用去離子水清洗 ELISA 板 5 次。向板中加入 100uL 底物,室溫孵育 5 分鐘。加入 100uL 終止液,用 SpectraMax ABS Plus 和 SpectraMax iD5 酶標儀測量樣品在 450nm 波長下的吸光度。
-
結果用 SoftMax Pro 軟件繪制黃曲霉毒素標準曲線,由 4、10、20 和 40 ppb 標準品組成(圖 2 和圖 3 )。軟件計算每個標準品的結合百分比( %B/B0 )。B 是每個標準品的平均吸光度值( OD ), B0 是 0 ppb 標準品的平均吸光度值。不含抗原的孔( B0 )吸光度值最大。使用 SoftMax Pro 軟件中的公式編輯器和分組表格計算 %B/B0 值和 Log (B/B0) 值。這些分析方法建立好后,保存為軟件中的模板,便于在將來的實驗中自動化分析數據結果。待測樣本中黃曲霉毒素的百分回收率通過標準曲線測得。10、20、30ppb 的三個待測樣本測得回收率在 71% 至 112% ,符合推薦的標準(表 1 )。
-
-
材料
-
AgraQuant Total Aflatoxin 4/40 ELISA 試劑盒 ( Romer Labs cat. #10002098 )
-
AflaStar R Rapid Clean-Up IAC 柱子 ( Romer Labs cat. #10001963 )
-
Aflatoxin B1 Standard 標準品 ( Sigma cat. #34029 )
-
Cannabis flower 大麻的花卉 ( 加州藥房獲取 )
-
Methanol, HPLC grade 甲醇,HPLC級 (Sigma cat. #34860)
-
Ammonium acetate 醋酸銨 ( Sigma cat. # 73594 )
-
SpectraMax ABS Plus 酶標儀 ( Molecular Devices )
-
SpectraMax iD5 多功能酶標儀 ( Molecular Devices )
制備樣品
將大麻樣本放在一個塑料袋里,用手壓碎。稱量 1 克樣本并將其放入 4 個 50mL 的錐形管中。然后在樣本中分別添加 0、10、20 和 30 ppb 黃曲霉毒素 B1 標準品。再加入 20mL 70% 甲醇至樣本中,劇烈渦旋 3 分鐘。所得提取物通過 Whatman 1 級濾紙過濾到干凈的 50mL 錐形管中。
在每一個提取、過濾得到的樣品中,吸取 4mL 至干凈的錐形管中,并加入 20 mL 去離子水。總的 24mL 溶液通過免疫親和層析柱( IAC )純化。樣品中的黃曲霉毒素與層析柱中的抗體選擇性結合。用 20mL 0.5M 醋酸銨沖洗柱子,將未結合的物質沖洗掉。最后用 1mL 100% 甲醇洗脫樣品,收集于干凈的試管中。
黃曲霉毒素 ELISA 檢測方法
每個標準品和待測樣品的稀釋孔做三個重復,放置于微孔板條固定器中。將等量抗體包被的微孔放置在單獨的板條固定器( ELISA 板)中。未使用的微孔放回帶有干燥劑的鋁箔袋中。
每個稀釋孔加入 100uL 的偶聯物,然后加入 50uL 黃曲霉毒素標準品或待測樣品。根據試劑盒方案,偶聯物與樣品保持 2 :1 的比例。孔內溶液用 8 通道移液器混合均勻。每種稀釋溶液取 100uL 轉移到 ELISA 板的抗體包被過的微孔中,室溫孵育 15 分鐘。
孵育后,用去離子水清洗 ELISA 板 5 次。向板中加入 100uL 底物,室溫孵育 5 分鐘。加入 100uL 終止液,用 SpectraMax ABS Plus 和 SpectraMax iD5 酶標儀測量樣品在 450nm 波長下的吸光度。







 熱門品牌
熱門品牌













